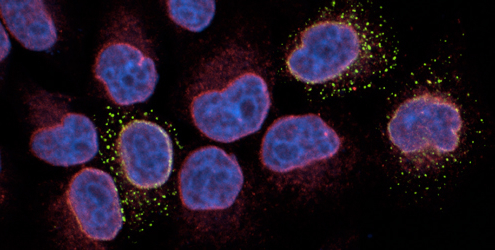

Bienvenue à la nouvelle équipe de l’IRIM
Laura PICAS, jeune biophysicienne et CR2 CNRS, rejoint l’IRIM…
https://www.irim.cnrs.fr/wp-content/uploads/LOGO_IRIM25-300x105.png
0
0
stephernandez
https://www.irim.cnrs.fr/wp-content/uploads/LOGO_IRIM25-300x105.png
stephernandez2017-07-10 09:43:162024-04-23 15:31:15ACCUEIL
Domaines membranaires et assemblage viral
Delphine Muriaux et Cyril Favard

AMI – Autophagie et Mécanismes associés dans les Infections
Lucile ESPERT et Mickaël BLAISE

Acteurs de la pathogenèse des infections rétrovirales
Bruno BEAUMELLE
Interféron et restriction antivirale
Caroline GOUJON

Trafic viral, restriction et immunité innée
Nathalie ARHEL et Sébastien NISOLE
https://www.irim.cnrs.fr/wp-content/uploads/equipe8.jpg
250
500
BONAZZI matteo
https://www.irim.cnrs.fr/wp-content/uploads/LOGO_IRIM25-300x105.png
BONAZZI matteo2017-07-04 14:52:492023-10-27 14:14:44Biologie Cellulaire et Moléculaire des Infections Bactériennes
https://www.irim.cnrs.fr/wp-content/uploads/equipe12.jpg
250
500
Laura PICAS
https://www.irim.cnrs.fr/wp-content/uploads/LOGO_IRIM25-300x105.png
Laura PICAS2017-07-04 14:52:492024-01-10 12:33:24Biologie quantitative du trafic membranaire et pathogenèse
Virus ARN et métabolisme
Laurence BRIANT et Jean-Luc BATTINI
